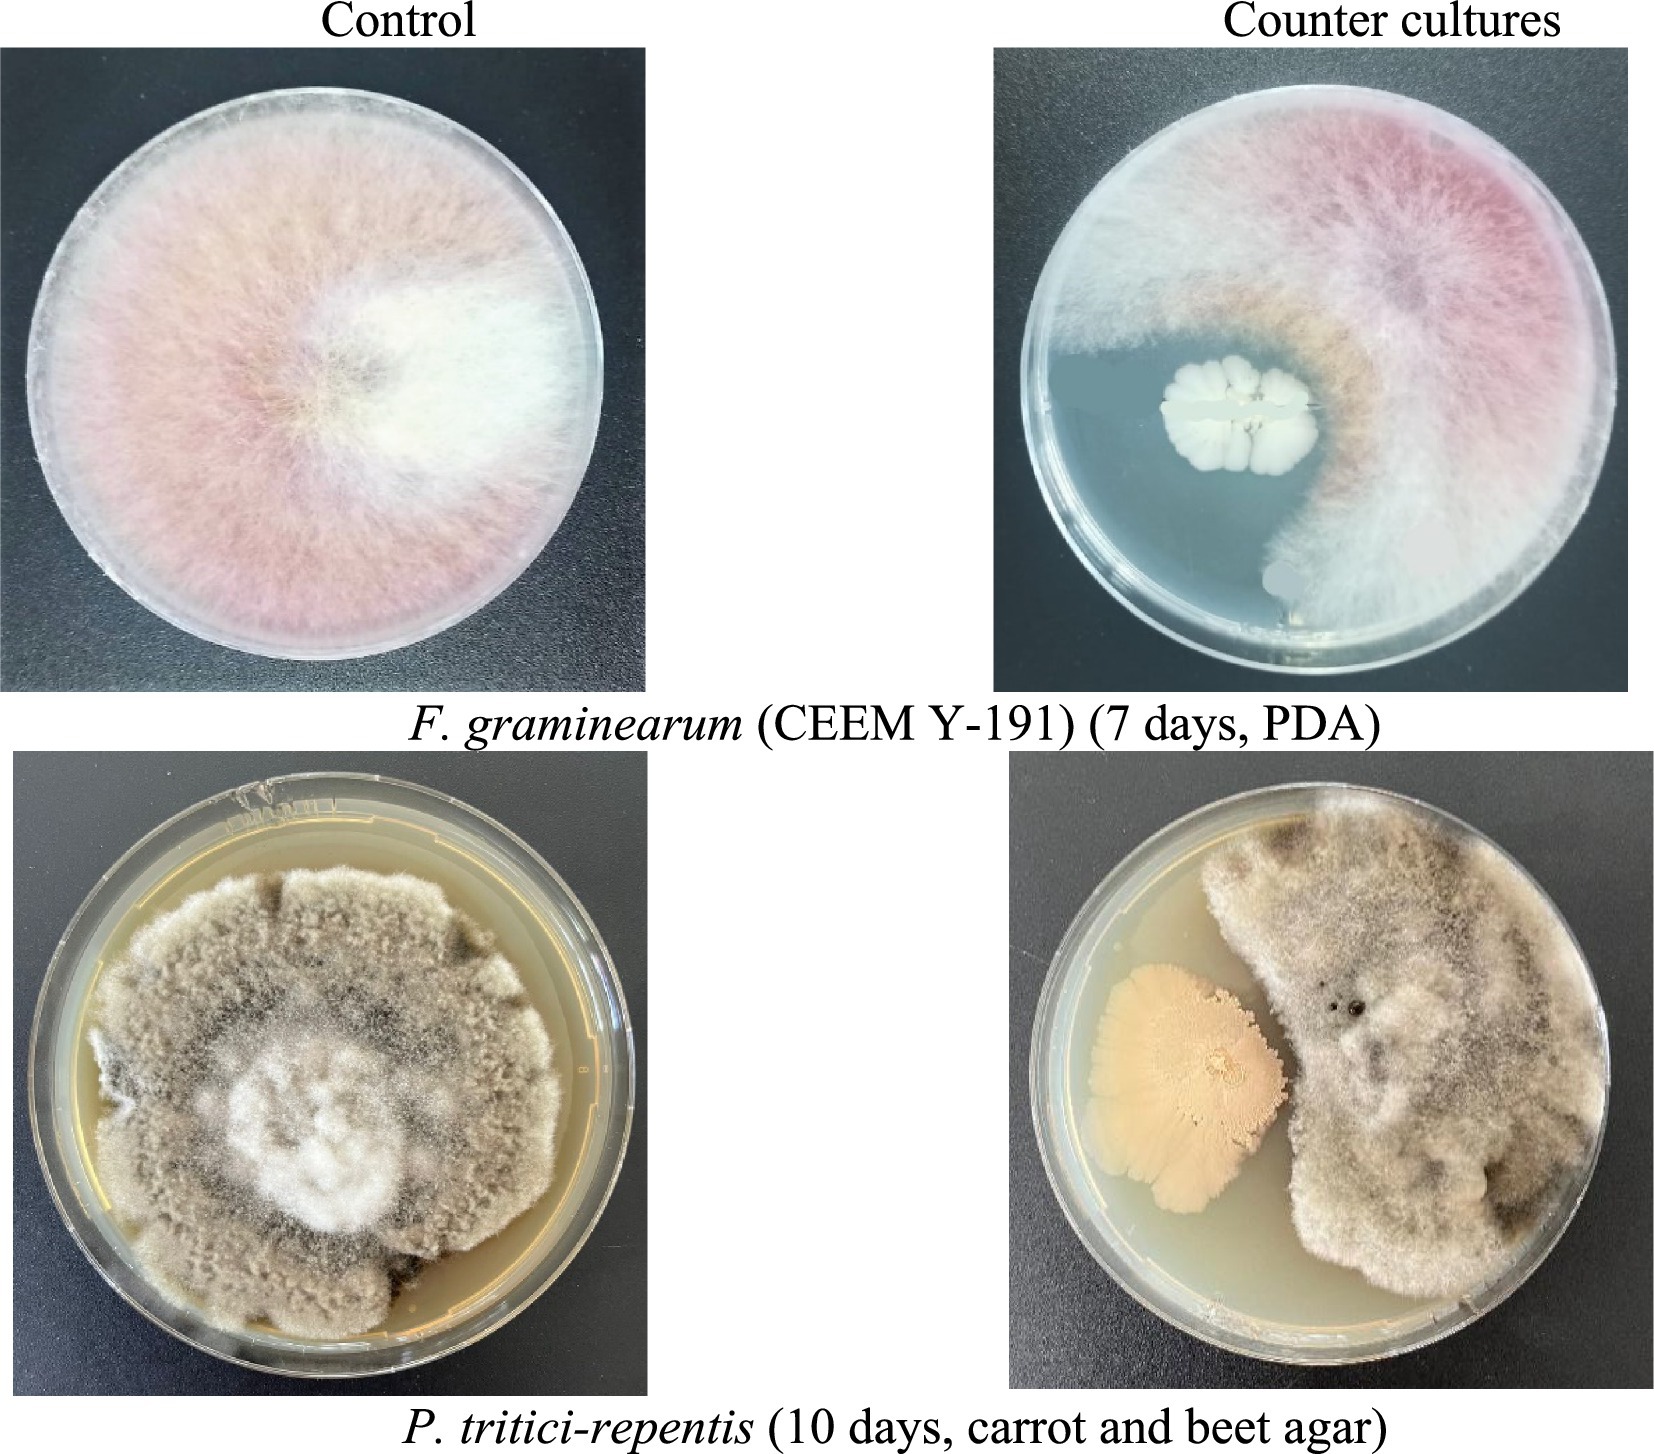

- 1Federal State Budgetary Educational Institution of Higher Education “Kuban State Agrarian University named after I. T. Trubilin”, Krasnodar, Russia
- 2Department of Environmental Management, Institute of Environmental Engineering, RUDN University, Moscow, Russia
The present study evaluated the efficacy of a novel strain of Bacillus subtilis Krd-20 (VKM B-3516D) (Ehrenberg 1835) Cohn 1872 in controlling common wheat diseases. The strain was isolated in 2020 from the surface soil layer of the wheat rhizosphere in the Krasnodar region of Russia and identified at the species level based on 16S rRNA gene sequencing. Mass spectrometric analysis, PCR with primers specific to the FenD, ItuD, and SrfC synthetase genes, as well as draft genome annotation using PGAP, revealed that the strain’s fungistatic activity is mediated by the production of lipopeptides—fengycin and surfactin. Furthermore, an experimental biofungicide formulation based on B. subtilis Krd-20 (VKM B-3516D), developed as a wettable powder, was tested in vivo for its efficacy in controlling fusarium head blight (FHB) and yellow leaf spot in wheat. Field trials demonstrated a biological efficacy of 75–83% for the biofungicide. Additionally, an assessment of its compatibility with the mineral fertilizer 18:18:18 “Universal” indicated minimal impact of mineral components on microbial viability, suggesting its potential integration into combined formulations. Mycological analysis of soil demonstrated that application of the biofungicide increased disease-suppressive properties in the rhizosphere by 21.1%. Evaluation of grain infestation revealed the lowest disease incidence in treatments combining the biofungicide with fertilizer. Furthermore, the application of the biofungicide resulted in a 2.5% increase in crop yield. These findings indicate that B. subtilis Krd-20 (VKM B-3516D) has significant potential as a biofungicide within wheat production systems, contributing to sustainable agriculture.
1 Introduction
Wheat is a globally cultivated staple crop of significant agricultural and economic importance (Igrejas and Branlard, 2020; Voučko et al., 2025). The demand for this grain continues to rise in response to the growing global population, which necessitates increased food production to ensure food security (Ray et al., 2013). As one of the primary sources of carbohydrates, proteins, and essential nutrients, wheat plays a crucial role in global diets and agricultural economies (Shewry and Hey, 2015).
However, fungal diseases—such as yellow leaf spot, septoria leaf blotch, powdery mildew, various rusts (yellow, brown, and stem), smut, black chaff, root and basal rot and snow mold—pose significant constraints to winter cereal production. These fungal pathogens are disseminated through diverse pathways, including untreated propagation material (e.g., seeds, cuttings, bulbs, tubers, rhizomes), contaminated or unfumigated soil, wind dispersal, water, and insect vectors. Furthermore, a warm and humid climate markedly accelerates the spread of these diseases, often leading to epidemic outbreaks (Rebouh et al., 2019; Temirbekova et al., 2022).
Fusarium head blight (FHB), also known as head smut, is among the most destructive diseases of wheat, barley, and maize, with significant implications on both crop yield and food safety. The disease is caused by various species of the genus Fusarium, including F. graminearum, F. avenaceum, F. culmorum, F. poae, and F. sporotrichioides. Among these, F. graminearum Schwabe (teleomorph = Gibberella zeae (Schw.) Petch) is recognized as the most prevalent and virulent pathogen worldwide (Thuraga et al., 2024).
Infection of cereal spikes by Fusarium spp. leads to the accumulation of mycotoxins in the grain. Consumption of contaminated grain poses serious health risks, including mycotoxicosis and other harmful mutagenic, teratogenic, and estrogenic effects in both humans and animals (Mielniczuk and Skwaryło-Bednarz, 2020). From an economic standpoint, FHB represents one of the most significant threats to global cereal production, frequently resulting in considerable yield losses and reduced grain quality.
To address these challenges, enhancing wheat yield and quality through effective management of biotic and abiotic stresses remains a fundamental objective in modern agricultural research and development (Arif et al., 2025; Ould Amer et al., 2023). However, these advancements must be achieved within the framework of sustainable and environmentally friendly farming systems to promote the conservation of natural resources and safeguard human health (Kherif et al., 2021).
In this regard, the use of biological methods for disease control has gained significant importance (Pandit et al., 2022). Currently, bacterial-based formulations account for approximately 80% of the global biofungicide market, with cereal production representing the largest share of these biopesticides (Sharma et al., 2020). Among the most effective bacterial agents used in biological fungicides are species of Pseudomonas migula 1894 and Bacillus. Within the Bacillus genus, the most commonly employed biocontrol preparations are based on B. subtilis and B. pumilus (Bonaterra et al., 2022; Dimkić et al., 2022; Rebouh et al., 2022).
The specificity of biopesticides varies considerably across different formulations and is influenced by multiple factors, including crop type, target pathogen, pedoclimatic conditions, and the unique characteristics of the biological agents employed. These factors collectively determine the efficacy and practical application of biopesticides, as their performance is highly context dependent (Ayilara et al., 2023).
For instance, the Russian market currently lacks a sufficient number of registered biopesticides based on B. subtilis that effectively protect grain crops from widespread disease outbreaks. Although the biopesticide Baktofit, SP (OOO PO Sibbiopharm, Russia), formulated with the B. subtilis strain IPM 215, exhibits suppressive activity against phytopathogens responsible for root rot, powdery mildew, septoria, and brown rust, it is not registered for controlling Pyrenophora tritici-repentis, the causal agent of yellow leaf spot (YLS), or Fusarium spp., which causes fusarium head blight (FHB) (Pavlyusin et al., 2020).
Similarly, the two-component biopesticide Vitaplan, SP (Federal State Budgetary Scientific Institution “All-Russian Research Institute for Plant Protection,” Russia), formulated with B. subtilis strains VKM -V-2604D and VKM -V-2605D, effectively suppresses pathogens causing spot form blotch and root rot (Fusarium spp. and Helminthosporium sp.) in barley (Shpanev and Denisyuk, 2020). However, it is not currently registered for use in wheat protection, highlighting a gap in the availability of effective biocontrol solutions for major wheat diseases in Russia.
Bacteria of the genus Bacillus are well known for their ability to synthesize lipopeptides as secondary metabolites. These lipopeptides exhibit potent fungistatic and fungicidal properties and are classified into three main families: surfactins, iturins, and fengycins (Hezakiel et al., 2024). As biosurfactants of non-ribosomal origin, lipopeptides possess amphiphilic properties that enable them to disrupt the structural integrity of biological membranes, a mechanism widely exploited in the biological control of plant pathogens (Saiyam et al., 2024). Furthermore, lipopeptides play a crucial role in plant protection by inducing systemic resistance, thereby enhancing the plant’s innate defense mechanisms (Chen et al., 2020). In addition to their direct antifungal activity, they can modulate plant immune responses, leading to increased resistance against a broad spectrum of phytopathogens (Ongena et al., 2005; Xiong et al., 2015). Their multifunctional nature, encompassing antimicrobial, immunomodulatory, and biofilm-disrupting properties, underscores their significance as key agents in sustainable disease management strategies in modern agriculture (Romero et al., 2007).
One of the key criteria for an effective biopesticide is its ability to form symbiotic complexes with plants, also known as endophytic properties. Microorganisms exhibiting endophytic characteristics have a significant advantage over saprophytic ones, as they are in continuous, direct contact with plant cells, thereby offering protection against pathogen-induced damage (Khan et al., 2022). Another critical feature of biopesticides is their compatibility with mineral fertilizers, specifically the absence of adverse effects of these chemicals on the viability of bacterial populations over extended periods. Research has demonstrated that the use of combined biological and mineral-based preparations offers the most effective approach for plant protection (Zhang et al., 2022).
Currently, evaluating the soil suppressiveness index has become an essential component of biopesticide testing. Suppressive soils harbour beneficial microorganisms capable of providing robust protection against a variety of soilborne diseases. The biocontrol potential of such soils is especially significant when considering phytopathogens such as Fusarium spp., as highlighted by Rebouh et al., 2020.
The objective of this study was to develop and evaluate an experimental biofungicide derived from a novel natural strain of B. subtilis Krd-20 VKM B-3516D for the biological control of major wheat diseases. Additionally, the study aimed to assess the compatibility of the biofungicide with mineral fertilizers. To achieve this, the B. subtilis strain was isolated from soil, and its fungistatic activity was initially assessed in vitro. Subsequently, the strain was formulated as a wettable powder and evaluated under field conditions to determine its efficacy and performance in practical applications.
2 Materials and methods
2.1 Isolating the antagonistic agent
A new natural strain of B. subtilis possessing antagonistic activity was isolated in 2020 from the surface soil layer of the wheat agrobiome in the Krasnodar region, Russia (The localization coordinates of the studied area are 45°3.80’N, 38°53.07′E geographic coordinates are given in WGS-84 format) (Kopyltsov, 2021).
The ARDRA method (amplified ribosomal DNA restriction analysis), which involves restriction analysis of the 16S ribosomal RNA region was used to identify the investigated strain. Specific primers K-B1f (5’-TCACCAAGGCAACGATGCG-3′) and K-B1r (5’-CGTATTCACCGCGGCATG-3′) were used to amplify the 16S rRNA region (Nagy et al., 2012), as well as Taq I restrictase (OOO SibEnzim, Russia). The gene sequences have been deposited in a publicly accessible repository and are available in GenBank under the accession number MW227473.1. Strain VKM B-3516D (=CEEM B-160) has been deposited in the All-Russian Collection of Microorganisms and in the Collection of Eubiotic and Epiphytic Microorganisms.1
2.2 Isolation of antifungal peptides
The acid precipitation method was employed to isolate antifungal peptides (Guo et al., 2014). Prior to this, the culture liquid was separated from the nutrient medium components Meat Peptone Agar (MPA) (AGATMED, Russia) and bacterial cells by centrifugation at 8,228 RCF x g for 15 min (5,804 R, Eppendorf, USA). To isolate lipopeptides, the culture was grown in a liquid nutrient medium with the following composition (g/L): beet molasses – 20, corn extract – 5, and defoamer – 25. Cultivation was carried out in an ES-20/60 orbital shaker incubator (Biosan, Latvia) at 7,24 RCF x g and 30 °C for 20 h. The resulting supernatant was then cooled to 4 °C, and hydrochloric acid (HCl) was added while stirring on a magnetic stirrer until the pH reached 2. The mixture was maintained at 4 °C for 5 h, followed by centrifugation at 8,228 RCF x g for 15 min (5,804 R, Eppendorf, USA). The supernatant was discarded, and the precipitate was redissolved in 1 mL of distilled water. The pH was 8–9. A twofold volume of cold acetonitrile was added to the solution, which was then stirred. After centrifugation, the supernatant containing lipopeptides was collected. Protein concentration was determined using the Bradford method, with bovine serum albumin as the standard (Bradford, 1976).
2.3 Identification of lipopeptides and evaluation of fungistatic properties
The acetonitrile solution after precipitate extraction was subjected to MALDI-TOF mass spectrometric analysis using an ULTRAFlex2 mass spectrometer (Bruker Daltonics, Germany). The extract of the nutrient medium without inoculation was used as a control. Mass spectra were obtained on a mass spectrometer with a 337 nm nitrogen laser at a pulse frequency of up to 20 Hz, as illustrated previously (Athukorala et al., 2009). A 0.5 μL sample was mixed on the target with an aliquot of 20% acetonitrile solution containing 0.1% trifluoroacetic acid and 20 mg/mL 2.5-dihydroxybenzoic acid and air-dried. Acetonitrile serves to reverse the polarity of the solvent, enabling the separation of proteins based on their hydrophobicity. Mass spectra were recorded in the range of 600–2000 m/z. To identify the molecules, the peak masses were compared with those in previously published literature (Pyoung et al., 2010). The fungistatic activity of lipopeptides was assessed by the counter-growth method with a test strain, F. graminearum KubGAU Y-191.2 Incubation spanned for 7 days at 28 °C (Tagg and McGiven, 1971).
A polymerase chain reaction (PCR) was performed to identify genes encoding fungistatic lipopeptide synthetases. The following primers: FenD1f (5’-TTTGGCAGCAGGAGAAGTTT-3′), FenD1r (5’-GCTGTCCGTTCTGCTTTTTC-3′), ItuD1f (5’-GATGCGATCTCCTTGGATGT-3′), ItuD1r (5’-ATCGTCATGTGCTGCTTGAG-3′), Sur3f (5’-ACAGTATGGAGGCATGGTC-3′), Sur3r (5’-TTCCGCCACTTTTTCAGTTT-3′), (Synthol, Russia) were used to identify the genes encoding fengycin, iturin, and surfactin synthetases, respectively. The following modes were used for FenD to amplify the product: initial denaturation for 3 min, 94 °С, 45 cycles of denaturation for 1 min, 94 °С, annealing for 1 min, 62 °С, elongation for 1 h 45 min at 72 °С and final elongation for 6 min at 72 °С. For the ItuD and SrfC primers the following regimes were used: initial denaturation – 94 °С, 15 min, 30 cycles of denaturation – 30 s, 94 °С, annealing – 30 s, 60 °С, elongation – 2 min, 72 °С, final elongation – 10 min, 72 °С. The PCR results were visualized via horizontal electrophoresis in 2% agarose gel placed in 1% TAE buffer at 120 V and 40 mA for 1 h. The sizes of the amplification products were determined in comparison with the DNA Ladder 1 kb molecular weight marker (Eurogen, Russia) (Kopyltsov, 2021).
2.4 Isolation of phytopathogens
The test strain used in the study was F. gramineаrum, isolated from a wheat spike. Fusarium spp. were identified using a taxonomic key indicating the principal morphological characteristics of colonies and spores. The inoculated wheat grain samples were inspected for external signs of prior infection with Fusarium spp. The grains were then sterilized with 70% ethyl alcohol for 1 min and washed with sterile water and then placed on dense Czapek nutrient medium. The grains were incubated at 28 °C for 5 days. Identification of fungi was carried out using light microscopy Olympus BX41 (Collinge et al., 2022). The strain was deposited in the Collection of Endophytic and Epiphytic Microorganisms (KubGAU Y-191).3
To isolate pure cultures of P. tritici-repentis, 3 × 5 mm pieces were excised from symptomatic wheat leaves exhibiting yellow leaf spot, capturing the edge of the spot and a small area of healthy tissue. The excised leaf material was washed under running water for 1 h, then the surface was sterilized with 2% copper sulfate for 5–10 min, then rinsed with sterile water and placed on carrot and beet agar (15% vegetable juice mixture). The cultures were initially incubated at 25 °С for 6 days to promote growth, then the temperature was finally adjusted to 15 °С for 2 days for conidia formation (Mikhailova et al., 2002). Strain identification was carried out using light microscopy distinguishing both macro- and micromorphological features.
To evaluate the fungistatic properties, a double cultivation method of the bacterial isolate with test strains F. graminearum and P. tritici-repentis was carried out. Culturing was carried out on dense PDA medium and V4 by the counter growth method at a distance of 30 mm from each other. The petri-dishes were incubated at 28 °C for 7 days. The growth of the pathogen and antagonist competing for feeding area in the Petri dish as well as the nature of their interaction were noted: the presence or absence of growth inhibition zones as a result of the activity of hydrolytic enzymes or antibiotic substances (sterile zone, mm); the growth of the antagonist per pathogen colony (hyperparasitic zone, cm2); the growth of the pathogen colony per antagonist colony, cm2 (Astapchuk, 2021).
2.5 Preparation of bacterial suspension
The following nutrient substrate was used for bacterial culturing in the BIORUS 100 L bioreactor for 2 days at 28 °С: molasses – 20 g / l, corn extract – 5 g/l, antifoam – 0.25 g/l. After the time had elapsed, the culture liquid was separated low-through centrifugation at 21826 RCF ×g (Biorus, Russia). The pH of the bioreactor ranges from 6.5 to 7.5. The separated microbial mass was mixed with a thermoprotector (potato starch and water at a ratio of 1: 5) and spray dried to obtain a dry preparative form of bacteria (Astapchuk, 2021). The amount of thermoprotector was at a 1:1 ratio to the microbial biomass.
2.6 Compatibility with mineral fertilizers
The compatibility of the B. subtilis Krd-20 VKM B-3516D biofungicide with mineral water-soluble fertilizers (hereinafter referred to as WSF) 18:18:18 “Universal” (“Uralchem,” Russia) was determined. A working solution was prepared following the manufacturer’s instructions, into which a spore suspension of B. subtilis VKM B-3516D was introduced. For the control treatment, the same spore suspension was added to sterile distilled water. The concentration of the bacterial inoculum was 1 × 1011 colony-forming units (CFU)/mL. For this purpose, the preparations were mixed in a proportion of 99:1. The number of microorganisms per 1 g of the preparation was estimated by tenfold dilutions in a physiological solution (NaCl, 0.9%) and subsequent colony counting on dense PDA medium. The experiment was repeated every other day for 1 year (Sameer, 2019).
2.7 Field trials
The studies were conducted during 2022–2024 in the Chernozem agricultural region of Russia, at the Experimental Station of Kuban State Agrarian University named after I.T. Trubilin, located in the central zone of Krasnodar Krai (45°3.80’N, 38°53.07′E). The winter wheat variety Bezostaya 100 was used in the study. Experimental plots were arranged in a randomized complete block design (RCBD) with three replicates to ensure statistical reliability and minimize variability. The trials were conducted following the established regional cropping system in terms of tillage, seeding rate, sowing, crop maintenance, and harvesting. Before sowing, the seeds were treated with the insecticide-fungicide seed treatment Vibrance Integral, KS (175 g/L Thiamethoxam + 25 g/L Sedaxan + 25 g/L Fludioxonil + 10 g/L Tebuconazole) at an application rate of 2 L/t. The chemical standard was the fungicide Elatus Ria, Syngenta (Prothioconazole + benzovindiflupyr + cyproconazole). The treatments were applied as foliar sprays, administered twice by spraying the aboveground parts of the plants using a handheld sprayer (model: Garden Sprayer “Osa-12 ER LUX” by Kamtools, Russia).
2.7.1 Experimental treatments
1. Application of 1% solution consisting of NPK 18:18:18 “Universal” combined with dry B. subtilis Krd-20 VKM B-3516D biofungicide on a ratio of 99:1 (application rate 2.7 kg/ha).
2. Application of 1% solution consisting of NPK 18:18:18 “Universal” 18:18:18 “Universal” (“Uralchem,” Russia).
3. Control – No treatment.
The mineral fertilizer and biofungicide were foliar applied twice during the heading phase (Patil and Chetan, 2018). Crop management included the application of selective herbicides at the post-emergence stage to control monocotyledonous weeds. Axial KE (50 g/L pinoxaden + 12.5 g/L cloquintocet-mexyl [antidote]) was applied at a rate of 1 L/ha. Cloquintocet-mexyl is an antidote commonly used in agriculture to protect cereal crops from herbicide-induced damage. It accelerates the detoxification of specific herbicides, enabling plants to more efficiently metabolize and eliminate them. This improves the selectivity of herbicides, enhancing their ability to target and control weeds without harming the cultivated crops.
Additionally, Derby, SK (75 g/L florasulam + 100 g/L flumetsulam) was applied at a rate of 0.06 L/ha for broadleaf weed suppression. For insect pest control, the combined insecticide Eforia, KS (106 g/L lambda-cyhalothrin + 141 g/L thiamethoxam) was applied at a rate of 0.2 L/ha.
During the 2022–2024 growing seasons, climatic conditions were relatively consistent, with lower average temperatures and increased precipitation during the winter wheat vegetation period. These conditions favored the development of crop diseases. To assess disease severity under natural infection pressure, the scale of Babayants was employed (Gagkaeva et al., 2018). Disease severity was determined based on the percentage of the leaf surface affected by lesions at the peak of disease development. Assessments were conducted during the heading phase—milky ripening.
The harvest was conducted in September using a Terrion SR2010 selection combine harvester. The direct combining method was employed to ensure efficient harvesting with minimal losses. To accurately measure yield, harvesting was performed on a plot-by-plot basis at a standardized grain moisture level of 14%, enabling a precise assessment of productivity across different field sections. Grain samples were collected for subsequent laboratory analysis to determine key quality parameters, including protein content, gluten content, moisture level, and other critical factors essential for assessing the commercial and nutritional value of the crop.
2.8 Mycological analysis of soil
The rhizosphere of the wheat field was analyzed for mycological composition. A 10 g soil sample was subjected to a tenfold serial dilution in a physiological solution and subsequently inoculated onto Czapek nutrient medium. The cultures were incubated at 28 °C for 7 days. Following incubation, colonies of both saprophytic and phytopathogenic fungi were enumerated and identified. Soil biotic suppressiveness against phytopathogens was assessed by calculating the ratio of suppressive fungal species to phytopathogenic species in the rhizosphere, determined by dividing the number of suppressive species by the number of phytopathogenic species (Mareckova et al., 2023). The precursor crop in the rotation system were maize and soybean in first and second years, respectively.
2.9 Grain contamination assessment
After harvesting, the grain underwent mycological analysis. The grain surfaces were sterilized with a 5% sodium hypochlorite solution for 3 min, followed by rinsing with sterile water. Under aseptic conditions in a laminar flow hood, the grains were placed in Petri dishes containing potato dextrose agar (PDA) supplemented with antibiotic solutions—streptomycin and Triton X-100 (0.02%) during preparation. The streptomycin was added at a ratio of 25 ug per 1 mL of nutrient agar, following the standard formulation. Following incubation in the dark at 24 °C for 7–14 days, the number of fungal colonies emerging from the grains was recorded. Species identification was determined based on a combination of macro- and micro-morphological characteristics recorded in specialized literature (Gagkaeva et al., 2021). Grain infestation by a specific taxon was quantified as the percentage of grains from which fungi of that taxon were isolated relative to the total number of grains analyzed. The relative abundance of a particular species was calculated as the percentage of isolates of that taxon in relation to the total fungal isolates of the genus. The reliability of the results was assessed through analysis of variance (ANOVA), enabling a comparative evaluation of experimental and control samples (Butkevičienė et al., 2021; Zhao et al., 2015). The level of statistical significance allowed for the analyses was 0.05.
2.10 Grain quality assessment
Grain quality parameters were assessed using standardized methodologies. Grain bulk density was determined using the PH-1MC Purka (LTK, Russia) in accordance with the manufacturer’s instructions. The mass of 1,000 grains was measured using the SLY-C Plus automatic seed counter (China), following the specified guidelines. Protein content, vitreousness, gluten content, gluten deformation index (GDI), and moisture content were analyzed using the InfraLUM FT-12 infrared analyzer (Lumex LLC, Russia) as per developer’s instructions.
2.11 Statistical analyses
All data were assessed for normality using XLSTAT (Premium Version, 2019, Addinsoft, Long Island, NY, USA). A one-way analysis of variance (ANOVA) was conducted to evaluate the effects of the investigated treatments on the studied variables. If the result of one-way ANOVA was p < 0.05, least significant difference was used to compare the differences between every two positions of plantar fascia. For least significant difference, p values we used had been corrected by the number of pairwise comparisons. Statistical difference was defined as p < 0.05.
3 Results
Based on the results of PCR analysis targeting the 16S rRNA gene region, the investigated strain was identified as belonging to the species B. subtilis. The strain has been deposited in the All-Russian Collection of Microorganisms at the G. K. Skryabin Institute of Biochemistry and Fundamental Medicine, Russian Academy of Sciences, and is registered under the accession number VKM B-3516D. The nucleotide sequence of a partial 16S rRNA gene has been deposited into the GenBank database under the accession number MW227473 (Kopyltsov, 2021).
3.1 Identification of lipopeptides and evaluation of fungistatic properties
The bacterial strain Krd-20 VKM B-3516D exhibited antifungal activity against phytopathogens when compared to the reference strain Bacillus sp. FEND1, which demonstrated fungistatic properties. MALDI-TOF-MS analysis identified mass ranges (m/z) of 1036.9 for surfactin and 1454.1 for fengycin, confirming the production of these cyclic lipopeptides by the strain under investigation. PCR amplification using primers FEND1F/R, ITUD1F/R, and SUR3F/R, followed by horizontal electrophoresis, revealed that the genome of the studied bacterial strain contains genes encoding the synthetases of the lipopeptides iturin and surfactin, but does not possess the gene for phenogicin synthetase (Figure 1).

Figure 1. Visualization of amplification products with primers ITUD1/R, SUR3F/R, FEND1F/R: 1–6 – reference strains of Bacillus sp. with fungistatic properties. СEEM B-209 Bacillus subtilis 01 – Carrier of the iturin, surfactin gene; СEEM B-210 Bacillus velezensis 02 – carrier of the surfactin gene; СEEM B-211 Bacillus velezensis 03 – carrier of the iturin, surfactin gene; СEEM B-212 Bacillus subtilis 04 – carrier of the iturin, surfactin gene; СEEM B-213 Bacillus halotolerans 05 – carrier of the iturin, surfactin gene; СEEM B-214 Bacillus velezensis 06 – carrier of the class D fengycin gene.
3.2 In vitro testing for disease biocontrol
The bacterial strain B. subtilis Krd-20 VKM B-3516D exhibited an antagonistic effect against Fusarium graminearum and Pyrenophora tritici-repentis during co-cultivation. The strain effectively inhibited the growth of both aerial and substrate mycelium, as demonstrated in Figure 2. In the presence of both pathogens, clear growth inhibition zones were observed, indicating the formation of sterile zones around the bacterial strain.
Figure 2. Growth inhibition of F. gramineárum and P. tritici-repentis by B. subtilis strain Krd-20 VKM B-3516D.
3.3 Compatibility of the biopesticide with fertilizers
The compatibility evaluation of the biological product derived from B. subtilis Krd-20 VKM B-3516D in combination with the 18:18:18 “Universal” and 12:6:36 “Final” fertilizers showed an initial viable microorganism count of 1.04 × 10^10 and 6.6 × 10^10 CFU/g, respectively, on day one of testing. After 12 months, the counts decreased to 1.2 × 10^9 and 2.8 × 10^9 CFU/g, respectively (Table 1). These results indicate that the mineral fertilizers had a negligible effect on the survival of the microorganisms, suggesting that these components can be effectively integrated into the production of combined formulations.

Table 1. Evaluation of the compatibility of B. subtilis Krd-20-based biofungicide and mineral fertilizers.
3.4 Assays for disease biocontrol
The final product obtained from the spray drying of B. subtilis Krd-20 VKM B-3516D biomass was a light brown powder, readily soluble in water. The number of viable microorganisms per 1 g of the preparation was 2 × 10^11 CFU/g.
The incidence of wheat diseases in the control plots was as follows: YLS-60% and fusarium head blight 20%. Studying the effect of the biopesticide produced from B. subtilis Krd-20 VKM B-3516D strain on the development of P. tritici-repentis (Figure 3) and F. gramineárum under field conditions, demonstrated that the biological efficiency achieved 83.4 and 75%, respectively (Table 2).

Figure 3. Spot-affected (left) and healthy (right) wheat leaves, depending on the experiment variant (natural infectious background).

Table 2. Biological efficacy of the B. subtilis VKM B-3516D SP biofungicide against P. tritici-repentis and F. graminearum under field conditions (2023–2024).
3.5 Soil biocontrol
In the context of evaluating the microorganism groups, 324 strains of pathogenic and opportunistic micromycetes from 9 genera were isolated and identified, with Aspergillus sp. and Penicillium sp. being the most predominant. The abundance of micromycetes varied significantly across the studied areas.
Table 3 presents the saprophytic and phytopathogenic microorganisms that developed from culturing a suspension of soil from the wheat rhizosphere on a nutrient medium, along with the number of colonies formed in each experimental treatment and the control.
The biotic soil suppressiveness index was lowest in plots treated solely with the mineral fertilizer 18:18:18:18 “Universal” (4.11 units), followed by the untreated control plots, which exhibited a suppressiveness value of 5.61 units. In contrast, experimental plots receiving both mineral fertilizers and the biofungicide demonstrated the highest suppressiveness index, reaching 21.11 units. This increase may be attributed to the ability of B. subtilis Krd-20 VKM B-3516D to inhibit the growth of both pathogenic and saprophytic microorganisms.
Thus, treatment of winter wheat plots with mineral fertilizers in combination with B. subtilis Krd-20 VKM B-3516D bacteria increases biotic suppressiveness of root zone soil, which leads to increased resistance of the wheat crop to phytopathogenic microorganisms.
3.6 Grain biocontrol, grain yield and quality
Culturing on a nutrient medium (PDA) led to the development of microorganisms such as Alternaria spp., Fusarium spp., and Helminthosporium sp. The graphs display the results of the grain infestation assessment (Figure 4), the yield from the experimental and control plots (Figure 5), and the primary grain quality indicators, including protein content, gluten content, grain hardness and grain nature (Figure 6).

Figure 4. Percentage of grain infection under different treatment conditions. p < 0.05 were deemed to be statistically significant.

Figure 5. Grain yield according to the tested treatments. p < 0.05 were deemed to be statistically significant.

Figure 6. Grain quality according to the tested treatments. Significant differences between pairs of groups after Bonferroni correction (p < 0.05) are indicated. *p > 0.05, **p < 0.01.
The research findings indicated that the highest number of pathogenic fungal colonies was observed in the treatment with only the mineral fertilizer, with infestation ranging from 30.0 to 56.7%. In contrast, the control plots exhibited a slightly lower percentage of grain infestation, ranging from 41.0 to 46.7%. However, the treatment involving the combination of the fertilizer and B. subtilis Krd-20 VKM B-3516D resulted in the lowest levels of infestation, ranging from 10.0 to 23.3%. Significant differences in grain contamination were observed (F = 5.8352, p = 0.0391) (Figure 4).
The highest grain yield was observed in the treatment combining fertilizers and the biofungicide, compared to lone fertilizer application or the control. However, analysis of variance revealed no significant differences between these results (F = 0.126, p = 0.883). Similarly, the highest grain quality was achieved with the biofungicide and fertilizer treatment. The protein content (F = 7.252, p = 0.0063) and gluten content (F = 8.1437, p = 0.004) were highest in the treatment combining biofungicide and fertilizers (Figure 6). However, there were no statistical differences in grain hardness (F = 0.806, 0.4651). There were differences in the grain-unit (F = 4.1034, 0.0293) (Figure 7).

Figure 7. Grain unit index measurement across different treatment conditions. p < 0.05 were deemed to be statistically significant.
The findings indicate that the biofungicide developed from the novel natural strain B. subtilis Krd-20 VKM B-3516D effectively controls common wheat diseases, increases yield by 2.5%, significantly improves grain quality and enhances rhizosphere biotic suppressiveness by 73.43% compared to the control.
4 Discussion
In the current study, the MALDI-TOF-MS analysis confirmed the production of cyclic lipopeptides by the studied strain (Krd-20 VKM B-3516D). These lipopeptides disrupt the cellular structure of phytopathogens by integrating into cell membranes, altering their permeability, and inducing resistance in plants (Hamoen et al., 2003; Villa-Rodriguez et al., 2021; Fira et al., 2018). Additionally, a liquid preparation of lipopeptides isolated from the bacterial culture supernatant inhibited the growth of F. graminearum CEEM Y-190. This demonstrates that the fungistatic effect of the bacteria is primarily due to the efficacy of the lipopeptides, as reported by Ramesh et al. (2024), who showed that the low minimum inhibitory concentrations of lipopeptides exhibit strong antifungal activity against several fungal strains.
PCR amplification using primers FEND1F/R, ITUD1F/R, and SUR3F/R, followed by visualization through horizontal electrophoresis, revealed that the genome of the studied bacterial strain contains genes encoding the synthetases for the lipopeptides iturin and surfactin, but lacks the gene for fengycin synthetase (Figure 1). The presence of the iturin gene, coupled with the absence of a corresponding signal in the MALDI-TOF-MS analysis, suggests that the gene, despite being present in the genome, is not determinative. This implies that the development of lipopeptide production is influenced not only by the presence of the gene but also by other factors, such as interactions with the environment (Schmidt et al., 2010). In the case of fengycin, an opposite scenario was observed: the MALDI-TOF-MS results indicated the presence of a spectrum, while PCR analysis showed the absence of the gene for fengycin group D production in the studied strain. This discrepancy may be attributed to several factors, including environmental conditions that induce the expression of lipopeptide biosynthesis pathways, including fengycin-like compounds, even in the absence of the corresponding gene detected by PCR, or a mutation in the corresponding nucleotide sequence (Yaseen et al., 2016). Additionally, the strain is capable of producing fengycins from other groups, such as fenC, fenE, fenA, and fenB, but does not produce fenD (Yin et al., 2024).
The most commonly used methods for isolating lipopeptides from culture fluid include acid precipitation at pH 2.0 (Torres et al., 2016), extraction with organic solvents (ethyl acetate, butanol) (Calvo et al., 2019), and salting out with ammonium sulfate (Alajlani et al., 2016). Comparative studies of these methods have shown that the spectra of the isolated lipopeptides are identical (Dimkić et al., 2022). In this study, acid precipitation was therefore selected as the method of isolation. The lipopeptides precipitated from the culture supernatant after extraction with acetonitrile were analyzed by time-of-flight mass spectrometry. The role of acetonitrile is to modify the polarity of the solvent, enabling the separation of proteins based on their hydrophobicity. MALDI-TOF mass spectrometric analysis of the lipopeptide solution in acetonitrile revealed two distinct clusters of molecules: one at m/z 1,022, 1,036, 1,044, 1,058, 1,060, and 1,074 (surfactin class) and another at m/z 1,464, 1,478, 1,492, and 1,506 (fengycin class). The observed differences of 14 Da between these peaks suggest the presence of homologous molecules with varying fatty acid chain lengths (CH2 = 14 Da), as previously reported by Pyoung et al., 2010. However, no peaks corresponding to iturin were detected. The MALDI-TOF spectrum revealed a predominance of the fengycin profile over the surfactin profile by approximately two times. In contrast, previous studies have presented spectra of these lipopeptides with inverse ratios, where surfactin predominated over fengycin (Sujata et al., 2016). The ratio of lipopeptides produced in B. subtilis cultures can vary significantly depending on factors such as the bacterial strain, growth conditions, and the specific genes involved in their biosynthesis. For instance, certain strains may predominantly produce fengycin, while others may favor the synthesis of surfactin (Yan et al., 2024).
The compatibility of biopesticides with chemical fertilizers is essential for their effectiveness, as chemical components can influence the biological agents incorporated into the biopesticide. The combined application of chemical fertilizers and bio-agents appears to enhance microbial populations and improve their dynamics (Bahadur et al., 2012; Sharma and Thivakaran, 2020).
The findings of the study indicate an insignificant effect of mineral fertilizers on the preservation of viable microorganisms when assessing the compatibility of the biofungicide developed from B. subtilis Krd-20 VKM B-3516D and fertilizers. These observations are consistent with those of several studies that have explored the interaction between biofungicides and fertilizers. For instance, Bueno et al. (2022) demonstrated that in soybean, incorporating a mineral fertilizer component of 25% led to the highest recovery of B. subtilis compared to the treatments with higher fertilizer constitutions of 50 and 100%. This suggests that a lower rate of mineral fertilizer may optimize the survival and proliferation of B. subtilis in the soil, potentially enhancing its effectiveness as a biofungicide without compromising its viability.
Sarkar and Rakshit (2023) investigated the compatibility of three bio-agents—Trichoderma harzianum, Pseudomonas fluorescens, and B. subtilis—both individually and in combination with chemical fertilizers to evaluate the combined effects of seedling bio-priming and fertilizer application on the fertility of red cabbage soil. They found that the inclusion of a dual-species bacterial consortium (P. fluorescens and B. subtilis) in the integrated system resulted in the highest dehydrogenase activity and available phosphorus compared to the sole application of chemical fertilizers. Additionally, a microbial consortium of T. harzianum and B. subtilis increased microbial biomass carbon and available potassium.
In our previous study (Rebouh et al., 2022), we assessed the effects of two environmentally friendly treatments on wheat yield components. The first treatment (T1) involved bioagents (B. subtilis and B. megaterium) combined with fertilizers, while the second treatment (T2) included fertilizers, bioagents, and reduced fungicide application rates. The results demonstrated that the combined treatment (T2) was more effective in enhancing grain yield and its components. This finding confirms the high compatibility of B. subtilis not only with chemical fertilizers but also with chemical fungicides.
The finding that mineral fertilizers had an insignificant effect on the preservation of viable B. subtilis Krd-20 VKM B-3516D aligns with existing literature, which suggests that biofungicides, particularly those based on Bacillus sp., are generally compatible with mineral fertilizers. This validates the potential for integrating biofungicides based on Bacillus spp. with conventional fertilizer application practices without significant adverse effects on microbial viability or biofungicide efficacy.
The introduction of new agricultural practices, such as the combined application of fertilizers and biological agents, into cropping systems must carefully consider their potential impacts on soil pathogens and other microorganisms (Baş, 2024; Sellami et al., 2025).
Soil mycological analysis in the present study indicated that the highest Soil Biotic Suppression Index was recorded in plots treated with B. subtilis Krd-20 RCM combined with mineral fertilizers. Conversely, the lowest suppressive effect was observed in plots treated exclusively with mineral fertilizers, followed by control plots, which received no treatment. This observation can be attributed to the ability of B. subtilis Krd-20 VKM B-3516D to inhibit the growth of both pathogenic and saprophytic microorganisms.
Several previous studies have highlighted the potential of B. subtilis in suppressing soil pathogens. Maslennikova et al. (2023) demonstrated that a bacterial mixture of B. subtilis and B. amyloliquefaciens effectively suppressed the plant-pathogenic fungus Rhizoctonia solani in the potato rhizosphere. Indeed, various B. subtilis strains have exhibited significant suppression capabilities against different pathogens, such as strain Z-14, which effectively controlled wheat take-all disease (Liu et al., 2022); strain E1R-j, by inhibiting Gaeumannomyces graminis in wheat seedlings (Liu et al., 2009); and strain B931, which significantly reduced rhizoctonia root rot of wheat (Ryder et al., 1998).
Moreover, despite B. subtilis having a high potential to suppress fungal pathogens in soils, it also promotes beneficial soil microorganisms, as reported by Rigobelo et al. (2024). The authors found that B. subtilis exhibited the highest species richness and diversity, as assessed by both Shannon and Gini-Simpson indices, in soybean soil samples, compared to T. harzianum.
Thus, the treatment of winter wheat plots with mineral fertilizers in combination with B. subtilis Krd-20 VKM B-3516D enhances the biotic suppressiveness of the root zone soil, thereby increasing the resistance of the wheat crop to phytopathogenic microorganisms.
Bacillus sp. have demonstrated their effectiveness in controlling common wheat diseases in several previous studies (Zhao et al., 2023; Rebouh et al., 2022; Mulk et al., 2022; Choudaker et al., 2024). These findings align with the results of the present study, where the treatment containing the strain B. subtilis Krd-20 VKM B-3516D significantly reduced grain infestation compared to both the control and the treatment in which fertilizers were applied alone.
The strain B. subtilis Krd-20 VKM B-3516D exhibits endophytic properties, as previously confirmed by Kopyltsov (2021). These properties appear to enhance seed productivity (Markova et al., 2024), stimulate the plant’s defensive response (Deng et al., 2019), and promote plant growth (Xu et al., 2020). Our results demonstrated that the treatment that included B. subtilis Krd-20 VKM B-3516D attained the highest grain yield. This is probably due to its ability to promote plant growth, enhance disease resistance and improve nutrient availability. The strain produces plant growth-promoting substances, such as phytohormones, that stimulate root development and enhance nutrient uptake, which is crucial for better plant growth and higher yields.
For instance, Yadav et al. (2023) reported that Bacillus sp., when applied alongside chemical fertilizers, not only stimulate plant growth but also improve yield and its attributes by enhancing nutrient availability and microbial activity in the wheat rhizosphere. Similarly, Chen et al., 2024 found that repeated inoculation with microbial inoculants, including Bacillus sp., leads to increased yield by enhancing nitrogen uptake and promoting Shannon diversity. Despite the observed influence of B. subtilis strains on grain yield in the present study, it is important to acknowledge the presence of multiple additional factors that may contribute to yield improvement. To more precisely isolate and quantify the contributions of individual factors to grain yield, future research should adopt multifactorial experimental designs combined with advanced statistical modeling, such as regression analysis or machine learning approaches. Additionally, integrating omics technologies (e.g., genomics, transcriptomics, metabolomics) with controlled environmental and genetic variables could provide deeper insights into the specific roles and interactions of microbial, environmental, and host plant factors.
Grain quality is a key indicator of cropping system effectiveness. Our results demonstrated that protein content, gluten content, and grain hardness were optimum under the treatment combining B. subtilis Krd-20 VKM B-3516D with fertilizers. This improvement can be attributed to the ability of B. subtilis to enhance plant nutrient uptake, which directly impacts grain quality (Ma et al., 2019; Yan et al., 2022). Furthermore, effective disease control plays a significant role in improving grain quality. El Chami et al. (2023) reported that increased Fusarium sp. infection adversely affects wheat quality by reducing protein content, test weight, thousand kernel weight, falling number, gluten content, and the Zeleny sedimentation index. In our study, higher grain quality was observed in the treatment containing B. subtilis, which aligns with these findings.
Thus, from a biological standpoint, the B. subtilis Krd-20 strain (VKM B-3516D) exhibits a multifaceted positive effect on plants. From an industrial perspective, its application as a biopesticide presents several key advantages. Notably, it enables the production of a bioproduct with a long shelf life without requiring additional manufacturing steps or the incorporation of stabilizing or preservative agents. Furthermore, the dry formulation of the biopesticide is particularly well-suited for long-term storage and transportation to remote or hard-to-reach regions.
5 Conclusion
The study demonstrated that the bacterial strain B. subtilis Krd-20 VKM B-3516D possesses significant antagonistic activity against the phytopathogenic microorganisms F. graminearum and P. tritici-repentis, inhibiting both aerial and substrate mycelial growth. Mass spectrometric analysis revealed the production of lipopeptides, fengycin and surfactin, which contribute to the fungistatic properties of the bacterium. Genome annotation using the PGAP method confirmed the presence of genes responsible for the synthesis of surfactin and iturin lipopeptides, while the fengycin-producing gene was absent. A bacterial preparation based on B. subtilis Krd-20 VKM B-3516D was produced on a semi-industrial scale, replicating key environmental conditions. Under field conditions, the biological efficacy of the dry biopesticide against YLS and FHB diseases in winter wheat reached 85%. Mycological analyses processing indicated that the application of the biopesticide, in combination with mineral fertilizers at a 1:99 ratio, enhanced the biotic suppressiveness of the wheat rhizosphere and improved the resistance of winter wheat to phytopathogenic infections. Moreover, the biofungicide and fertilizer treatment had a significant effect on yield and grain quality, as indicated by protein and gluten content, according to the ANOVA analysis (p > 0.05). Therefore, the developed biofungicide represents a promising tool for promoting the transition to environmentally friendly agricultural systems, offering a sustainable alternative to conventional chemical pesticides. Its application may contribute to the advancement of organic farming practices and support the development of a global green economy.
Data availability statement
The original contributions presented in the study are included in the article/supplementary material, further inquiries can be directed to the corresponding author.
Author contributions
SK: Data curation, Writing – original draft. IA: Writing – original draft, Methodology. AE: Writing – original draft, Project administration. LN: Writing – original draft, Resources. NK: Writing – review & editing, Data curation. OK: Software, Writing – original draft. AU: Investigation, Writing – original draft. NR: Writing – review & editing, Writing – original draft, Validation.
Funding
The author(s) declare that financial support was received for the research and/or publication of this article. This work was supported by the Kuban State Agrarian University named after I. T. Trubilin,” Krasnodar. The study of the compatibility of the bacterial preparation with fertilizers was carried out as part of the ‘UMNIK-URALKHIM’ competition with the support of LLC ‘Foundation for Assistance to Innovations’ and LLC ‘URALKHIM Innovation’ in 2022. This Publication has been supported by the RUDN University Scientific Projects Grant System, project no. 202787-2-000.
Conflict of interest
The authors declare that the research was conducted in the absence of any commercial or financial relationships that could be construed as a potential conflict of interest.
Generative AI statement
The authors declare that no Gen AI was used in the creation of this manuscript.
Any alternative text (alt text) provided alongside figures in this article has been generated by Frontiers with the support of artificial intelligence and reasonable efforts have been made to ensure accuracy, including review by the authors wherever possible. If you identify any issues, please contact us.
Publisher’s note
All claims expressed in this article are solely those of the authors and do not necessarily represent those of their affiliated organizations, or those of the publisher, the editors and the reviewers. Any product that may be evaluated in this article, or claim that may be made by its manufacturer, is not guaranteed or endorsed by the publisher.
Footnotes
1. ^https://mb.kubsau.ru/catalog/bakterii/bacillus/subtilis-subsp-subtilis/ceem-b-160/
2. ^https://mb.kubsau.ru/catalog/griby/fusarium/graminearum/ceem-y-191/
3. ^https://mb.kubsau.ru/catalog/griby/fusarium/graminearum/ceem-y-191/
References
Alajlani, M., Shiekh, A., Hasnain, S., and Brantner, A. (2016). Purification of bioactive lipopeptides produced by Bacillus subtilis strain BIA. Chromatographia 79, 1527–1532. doi: 10.1007/s10337-016-3164-3
Arif, M., Haroon, M., Nawaz, A. F., et al. (2025). Enhancing wheat resilience: biotechnological advances in combating heat stress and environmental challenges. Plant Mol. Biol. 115:41. doi: 10.1007/s11103-025-01569-7
Astapchuk, I. (2021). Antifungal activity of microbiological drugs in relation to pathogens from the genus Fusarium link. Bio Web Conf. 34:04012. doi: 10.1051/bioconf/20213404012
Athukorala, S. N., Fernando, W. D., and Rashid, K. Y. (2009). Identification of antifungal antibiotics of Bacillus species isolated from different microhabitats using polymerase chain reaction and MALDI-TOF mass spectrometry. Can. J. Microbiol. 55, 1021–1032. doi: 10.1139/W09-067
Ayilara, M. S., Adeleke, B. S., Akinola, S. A., Fayose, C. A., Adeyemi, U. T., Gbadegesin, L. A., et al. (2023). Biopesticides as a promising alternative to synthetic pesticides: a case for microbial pesticides, phytopesticides, and nanobiopesticides. Front. Microbiol. 14:1040901. doi: 10.3389/fmicb.2023.1040901
Bahadur, L., Tiwari, D. D., Mishra, J., and Gupta, B. R. (2012). Effect of integrated nutrient management on yield, microbial population and changes in soil properties under rice-wheat cropping system in sodic soil. J. Indian Soc. Soil Sci. 60, 326–329.
Baş, B. (2024). Bioprotection by natural sources for sustainable agriculture. Gaziantep, Turkey: IntechOpen.
Bonaterra, A., Badosa, E., Daranas, N., Francés, J., Roselló, G., and Montesinos, E. (2022). Bacteria as biological control agents of plant diseases. Microorganisms 10:1759. doi: 10.3390/microorganisms10091759
Bradford, M. M. (1976). Rapid and sensitive methods for the quantification of microgram quantities of protein utilizing the principle of protein-dye binding. Anal. Biochem. 72, 248–254.
Bueno, C. B., dos Santos, R. M., de Souza Buzo, F., Andra Silva, M. S. R., and Rigobelo, E. C. (2022). Effects of chemical fertilization and microbial inoculum on Bacillus subtilis colonization in soybean and maize plants. Front. Microbiol. 13:901157. doi: 10.3389/fmicb.2022.901157
Butkevičienė, L. M., Skinulienė, L., Auželienė, I., Bogužas, V., Pupalienė, R., and Steponavičienė, V. (2021). The influence of long-term different crop rotations and monoculture on weed prevalence and weed seed content in the soil. Agronomy 11:1367. doi: 10.3390/agronomy11071367
Calvo, H., Mendiara, I., Arias, E., Blanco, D., and Venturini, M. E. (2019). The role of iturin a from B. amyloliquefaciens BUZ-14 in the inhibition of the most common postharvest fruit rots //food. Microbiology 82, 62–69. doi: 10.1016/j.fm.2019.01.010
Chen, M., Author, W. N. C., Author, L. F. C., Zhu, Y., and Chen, Z. (2020). Biocontrol of tomato bacterial wilt by the new strain Bacillus velezensis FJAT-46737 and its lipopeptides. BMC Microbiol. 20:160. doi: 10.1186/s12866-020-01851-2
Chen, Y., Zang, H., Bai, L., Lv, C., Chen, X., Li, S. H., et al. (2024). Repeated inoculations improve wheat yield through modifying the rhizobacterial communities and nitrogen and phosphorus fractions. Appl. Soil Ecol. 196:105287. doi: 10.1016/j.apsoil.2024.105287
Choudaker, K. R., Singh, V. K., Kashyap, A. S., Patel, A. V., Sameriya, K. K., Yadav, D., et al. (2024). Evaluating the efficacy of microbial antagonists in inducing resistance, promoting growth, and providing biological control against powdery mildew in wheat. Front. Microbiol. 15:1419547. doi: 10.3389/fmicb.2024.1419547
Collinge, D. B., Jensen, D. F., Rabiey, M., Sarrocco, S., Shaw, M. W., and Shaw, R. H. (2022). Biological control of plant diseases–what has been achieved and what is the direction? Plant Pathol. 71, 1024–1047. doi: 10.1111/ppa.13555
Deng, Y., Chen, H., Li, C., et al. (2019). Endophyte Bacillus subtilis evade plant defense by producing lantibiotic subtilomycin to mask self-produced flagellin. Commun Biol 2:368. doi: 10.1038/s42003-019-0614-0
Dimkić, I., Janakiev, T., Petrović, M., Degrassi, G., and Fira, D. (2022). Plant-associated Bacillus and Pseudomonas antimicrobial activities in plant disease suppression via biological control mechanisms-a review. Physiol. Mol. Plant Pathol. 117:101754. doi: 10.1016/j.pmpp.2021.101754
El Chami, J., El Chami, E., Tarnawa, Á., and Kassai, K. M. (2023). Effect of fusarium infection on wheat quality parameters. Cereal Res. Commun. 51, 179–187. doi: 10.1007/s42976-022-00295-w
Fira, D., Dimkic, I., Beric, T., Lozo, J., and Stankovic, S. (2018). Biological control of plant pathogens by Bacillus species. J. Biotechnol. 285, 44–55. doi: 10.1016/j.jbiotec.2018.07.044
Gagkaeva, T., Orina, A., and Gavrilova, O. (2021). Fusarium head blight in the Russian Far East: 140 years after description of the ‘drunken bread’ problem. PeerJ 9:e12346. doi: 10.7717/peerj.12346
Gagkaeva, T. Y., Orina, A. S., Gavrilova, O. P., Ablova, I. B., and Bespalova, L. A. (2018). Characterization of winter wheat varieties for resistance to fusarium grain infection. J. Genet. Breed. 6, 685–692. doi: 10.18699/VJ18.411
Guo, Q., Dong, W., Li, S., Lu, X., Weng, P., Zhang, X., et al. (2014). Fengycin produced by Bacillus subtilis NCD-2 plays a major role in the biocontrol of cotton seedling damping-off disease. Microbiol. Res. 169, 533–540. doi: 10.1016/j.micres.2013.12.001
Hamoen, L. W., Venema, G., and Kuipers, O. P. (2003). Controlling competence in Bacillus subtilis: shared use of regulators. Microbiology 149, 9–17. doi: 10.1099/mic.0.26003-0
Hezakiel, H. E., Thampi, M., Rebello, S., and Sheikhmoideen, J. M. (2024). Biopesticides: a green approach towards agricultural pests. Appl. Biochem. Biotechnol. 196, 5533–5562. doi: 10.1007/s12010-023-04765-7
Igrejas, G., and Branlard, G. (2020). “The importance of wheat” in Wheat quality for improving processing and human health. eds. G. Igrejas, T. Ikeda, and C. Guzmán (Cham: Springer).
Khan, A. R., Mustafa, A., Hyder, S., Valipour, M., Rizvi, Z. F., Gondal, A. S., et al. (2022). Bacillus sp. as bioagents: uses and application for sustainable agriculture. Biology 11:1763. doi: 10.3390/biology11121763
Kherif, O., Keskes, M. I., Pansu, M., Ouaret, W., Rebouh, Y. N., Dokukin, P., et al. (2021). Agroecological modeling of nitrogen and carbon transfers between decomposer micro-organisms, plant symbionts, soil and atmosphere in an intercropping system. Ecol. Model. 440:109390. doi: 10.1016/j.ecolmodel.2020.109390
Kopyltsov, S. V. (2021). Bacillus subtilis for biological protection of Taxus baccata L. in landscape gardens. E3S Web Conf. 285:02002. doi: 10.1051/202128502002
Liu, B., Qiao, H., Huang, L., Buchenauer, H., Han, Q., Kang, Z., et al. (2009). Biological control of take-all in wheat by endophytic Bacillus subtilis E1R-j and potential mode of action. Biol. Control 49, 277–285. doi: 10.1016/j.biocontrol.2009.02.007
Liu, Z., Xiao, J., Zhang, X., Dou, S., Gao, T., Wang, D., et al. (2022). Influence of Bacillus subtilis strain Z-14 on microbial communities of wheat rhizospheric soil infested with Gaeumannomyces graminis var. tritici. Front. Microbiol. 13:923242. doi: 10.3389/fmicb.2022.923242
Ma, G., Liu, W., Li, S., Zhang, P., Wang, C., Lu, H., et al. (2019). Determining the optimal N input to improve grain yield and quality in winter wheat with reduced apparent N loss in the North China plain. Front. Plant Sci. 10:181. doi: 10.3389/fpls.2019.00181
Mareckova, M., Omelka, M., and Kopecky, J. (2023). The golden goal of soil management: disease-suppressive soils. Phytopathology 113, 741–752. doi: 10.1094/PHYTO-09-22-0324-KD
Markova, O., Garipova, S., Chistoedova, A., Matyunina, V., Lubyanova, A., Lastochkina, O., et al. (2024). Predicting field effectiveness of endophytic Bacillus subtilis inoculants for common bean using morphometric and biochemical markers. Plants 13:1769. doi: 10.3390/plants13131769
Maslennikova, V. S., Tsvetkova, V. P., Shelikhova, E. V., Selyuk, M. P., Alikina, T. Y., Kabilov, M. R., et al. (2023). Bacillus subtilis and Bacillus amyloliquefaciens mix suppresses rhizoctonia disease and improves rhizosphere microbiome, growth and yield of potato (Solanum tuberosum L.). J. Fungi 9:1142. doi: 10.3390/jof9121142
Mielniczuk, E., and Skwaryło-Bednarz, B. (2020). Fusarium head blight, mycotoxins and strategies for their reduction. Agronomy 10:509. doi: 10.3390/agronomy10040509
Mikhailova, L. A., Gultyaeva, E. I., and Kokorina, I. M. (2002). Laboratory methods for cultivating the causative agent of wheat yellow spot Pyrenophora tritici-repentis. Mycol. Phytopathol. 36, 63–67. doi: 10.1051/e3sconf/202128502002
Mulk, S., Wahab, A., Yasmin, H., Mumtaz, S., El-Serehy, H. A., Khan, N., et al. (2022). Prevalence of wheat associated Bacillus sp. and their bio-control efficacy against fusarium root rot. Front. Microbiol. 12:798619. doi: 10.3389/fmicb.2021.798619
Nagy, A., Manczinger, L., Tombácz, D., Hatvani, L., Gyõrfi, J., Antal, Z., et al. (2012). Biological control of oyster mushroom green mould disease by antagonistic Bacillus species. Biol. control fungal Bact. Plant Pathog. IOBC-WPRS Bull 78, 289–293.
Ongena, M., Jacques, P., Toure, Y., Destain, J., Jabrane, A., and Thonart, P. (2005). Involvement of fengycin-type lipopeptides in the multifaceted biocontrol potential of Bacillus subtilis. Appl. Microbiol. Biotechnol. 69, 29–38. doi: 10.1007/s00253-005-1940-3
Ould Amer, S., Aliat, T., Kucher, D. E., Bensaci, O. A., and Rebouh, N. Y. (2023). Investigating the potential of arbuscular mycorrhizalfungi in mitigating water deficit effects on durum wheat (Triticum durum Desf.). Agriculture 13:552. doi: 10.3390/agriculture13030552
Pandit, M. A., Kumar, J., Gulati, S., Bhandari, N., Mehta, P., Katyal, R., et al. (2022). Major biological control strategies for plant pathogens. Pathogens 11:273. doi: 10.3390/pathogens11020273
Pavlyusin, V. A., Novikova, I. I., and Boikova, I. V. (2020). Microbiological control in phytosanitary optimization technologies for agroecosystems: research and practice (review). Agric. Biol 55, 421–438. doi: 10.15389/agrobiology.2020.3.421eng
Pyoung, K., Ryu, J., Kim, Y., and Ch, Y. (2010). Production of biosuractant lipopeptides iturin a, fengycin and surfactin a from Bacillus subtilis CMB32 for the control of Colletotrichum gloeosporioides. J. Microbiol. Biotechnol. 20, 138–145. doi: 10.4014/jmb.0905.05007
Ramesh, S., Roy, U., Roy, S., and Rudramurthy, S. M. (2024). A promising antifungal lipopeptide from Bacillus subtilis: its characterization and insight into the mode of action. Appl. Microbiol. Biotechnol. 108:161. doi: 10.1007/s00253-023-12976-5
Ray, D. K., Mueller, N. D., West, P. C., and Foley, J. A. (2013). Yield trends are insufficient to double global crop production by 2050. PLoS One 8:e66428. doi: 10.1371/journal.pone.0066428
Rebouh, N. Y., Aliat, T., Polityko, P. M., Kherchouche, D., Boulelouah, N., Temirbekova, S. K., et al. (2022). Environmentally friendly wheat farming: biological and economic efficiency of three treatments to control fungal diseases in winter wheat (Triticum aestivum L.) under field conditions. Plants 11:1566. doi: 10.3390/plants11121566
Rebouh, N. Y., Latati, M., Polityko, P., Kucher, D., Hezla, L., Norezzine, A., et al. (2020). Influence of three cultivation technologies to control fusarium spp. in winter wheat (Triticum aestivum L.) production under Moscow conditions. Res. Crops 1, 17–25. doi: 10.31830/2348-7542.2020.003
Rebouh, N. Y., Polityko, P. M., Pakina, E., Plushikov, V. G., Norezzine, A., Gadzhikurbanov, A., et al. (2019). Impact of three integrated crop protection treatments on the varieties of winter wheat (Triticum aestivum L.) in Moscow area, Russia. Research on. Crops 20, 161–168. doi: 10.31830/2348-7542.2019.022
Rigobelo, E. C., de Andrade, L. A., Santos, C. H. B., Frezarin, E. T., Sales, L. R., de Carvalho, L. A. L., et al. (2024). Effects of Trichoderma harzianum and Bacillus subtilis on the root and soil microbiomes of the soybean plant INTACTA RR2 PRO™. Front. Plant Sci. 15:1403160. doi: 10.3389/fpls.2024.1403160
Romero, D., de Vicente, A., Rakotoaly, R. H., and Dufour, S. E., (2007). Veening, J. W., Arrebola, E., Cazorla, F., Kuipers, O. P., Paquot, M., and Perez-Garcia, P. ().The iturin and fengycin families of lipopeptides are key factors in antagonism of Bacillus subtilis toward Podosphaera fusca. Mol. Plant-Microbe Interact. 20:430–440. doi: 10.1094/MPMI-20-4-0430
Ryder, M. H., Yan, Z. H., Terrace, T. E., Rovira, A. D., Tang, W., and Correll, R. L. (1998). Use of strains of Bacillus isolated in China to suppress take-all and rhizoctonia root rot, and promote seedling growth of glasshouse-grown wheat in Australian soils. Soil Biol. Biochem. 31, 19–29. doi: 10.1016/S0038-0717(98)00095-9
Saiyam, D., Dubey, A., Malla, M. A., and Kumar, A. (2024). Lipopeptides from Bacillus: unveiling biotechnological prospects-sources, properties, and diverse applications. Braz. J. Microbiol. 55, 281–295. doi: 10.1007/s42770-023-01228-3
Sameer, W. M. (2019). Compatibility of biological control agents with fungicides against root rot diseases of wheat. Al-Azhar J. Agric. Res 44, 146–155. doi: 10.21608/ajar.2019.102808
Sarkar, D., and Rakshit, A. (2023). Amalgamation of farmers' bio-priming knowledge in integrated nutrient management for sustainable management of red cabbage soil under middle Gangetic Plains, India. Environ. Manag. 72, 382–395. doi: 10.1007/s00267-022-01638-3
Schmidt, J. W., Greenough, A., Burns, M., Luteran, A. E., and Mccafferty, D. G. (2010). Generation of ramoplanin-resistant Staphylococcus aureus. FEMS Microbiol. Lett. 310, 104–111. doi: 10.1111/j.1574-6968.2010.02051.x
Sellami, M. H., Mola, I. D., and Mori, M. (2025). Evaluating wheat response to biostimulants: a 25-year review of field-based research (2000–2024) front. Sustain. Food Syst 28:981. doi: 10.3389/fsufs.2025.1543981
Sharma, A., Shukla, A., Attri, K., Kumar, M., Kumar, P., Suttee, A., et al. (2020). Global trends in pesticides: a looming threat and viable alternatives. Ecotoxicol. Environ. Saf. 201:110812. doi: 10.1016/j.ecoenv.2020.110812
Sharma, S. B., and Thivakaran, G. A. (2020). Microbial dynamics in traditional eco-knowledge Vis-à-Vis chemical-intensive Agri-amendment systems of stress prone semi-arid tropics. Appl. Soil Ecol. 155:103668. doi: 10.1016/j.apsoil.2020.103668
Shewry, P. R., and Hey, S. J. (2015). The contribution of wheat to human diet and health. Food Energy Secur 4, 178–202. doi: 10.1002/fes3.64
Shpanev, A. M., and Denisyuk, E. S. (2020). Efficiency of microbial preparations based on Bacillus subtilis and Trichoderna harzianum for the protection of spring barley from diseases in northwestern Russia. Appl. Biochem. Microbiol. 56:930. doi: 10.1134/S0003683820090082
Sujata, S., Sanket, J., and Geetha, S. J. (2016). Lipopeptide production by Bacillus subtilis R1 and its possible applications. Braz. J. Microbiol. 47, 955–964. doi: 10.1016/j.bjm.2016.07.006
Tagg, J. R., and McGiven, A. R. (1971). Assay system for bacteriocins. Appl. Microbiol. 21, 943–948.
Temirbekova, S. K., Kulikov, I. M., Ashirbekov, M. Z., Afanasyeva, Y. V., Beloshapkina, O. O., Tyryshkin, L. G., et al. (2022). Evaluation of wheat resistance to snow Mold caused by Microdochium nivale (Fr) Samuels and I.C. Hallett under abiotic stress influence in the central non-black earth region of Russia. Plants 11:699. doi: 10.3390/plants11050699
Thuraga, V., Ghadamgahi, F., Dadi, F. A., Vetukuri, R. R., and Chawade, A. (2024). A new bacterial consortia for management of fusarium head blight in wheat. Sci. Rep. 14:10131. doi: 10.1038/s41598-024-60356-4
Torres, M. J., Perez Brandan, C., Petroselli, G., Erra-Balsells, R., and Audisio, M. C. (2016). Antagonistic effects of Bacillus subtilis subsp. subtilis and B. amyloliquefaciens against Macrophomina phaseolina: SEM study of fungal changes and UV-MALDI-TOF MS analysis of their bioactive compounds. Microbiol. Res. 182, 31–39. doi: 10.1016/j.micres.2015.09.005
Villa-Rodriguez, E., Moreno-Ulloa, A., Castro-Longoria, E., Parra-Cota, F. I., and de los Santos-Villalobos, S. (2021). Integrated omics approaches for deciphering antifungal metabolites produced by a novel Bacillus species, B. Cabrialesii TE3T, against the spot blotch disease of wheat (Triticum turgidum L. subsp. durum). Microbiol. Res. 251:126826. doi: 10.1016/j.micres.2021.126826
Voučko, B., Bartkiene, E., Rakszegi, M., and Rocha, J. M. F. (2025). Editorial: wheat: from nutrition to cultivation and technology. Front. Nutr. 12:1563397. doi: 10.3389/fnut.2025.1563397
Xiong, H. Q., Li, Y. T., Cai, Y. F., Cao, Y., and Wang, Y. (2015). Isolation of Bacillus amyloliquefaciens JK6 and identification of its lipopeptides surfactin for suppressing tomato bacterial wilt. RSC Adv. 5, 82042–82049. doi: 10.1039/C5RA13142A
Xu, J. X., Li, Z. Y., Lv, X., Yan, H., and Zhou, G. Y. (2020). Isolation and characterization of Bacillus subtilis strain 1-L-29, an endophytic bacterium from Camellia oleifera with antimicrobial activity and efficient plant-root colonization. PLoS One 15:e0232096. doi: 10.1371/journal.pone.0232096
Yadav, R. C., Sharma, S. K., Varma, A., Singh, U. B., Kumar, A., Bhupenchandra, I., et al. (2023). Zinc-solubilizing Bacillus sp. in conjunction with chemical fertilizers enhance growth, yield, nutrient content, and zinc biofortification in wheat crop. Front. Microbiol. 14:1210938. doi: 10.3389/fmicb.2023.1210938
Yan, L., Li, G., Liang, Y., Tan, M., Fang, J., Peng, J., et al. (2024). Co-production of surfactin and fengycin by Bacillus subtilis BBW1542 isolated from marine sediment: a promising biocontrol agent against foodborne pathogens. J. Food Sci. Technol. 61, 563–572. doi: 10.1007/s13197-023-05864-3
Yan, S.h., Wu, Y., Fan, J., Zhang, F., Guo, J., Zheng, J., et al. (2022). Quantifying grain yield, protein, nutrient uptake and utilization of winter wheat under various drip fertigation regimes. Agric. Water Manag. 261:107380. doi: 10.1016/j.agwat.2021.107380
Yaseen, Y., Gancel, F., Drider, D., Béchet, M., and Jacques, P. (2016). Influence of promoters on the production of fengycin in Bacillus sp. Res. Microbiol. 167, 272–281. doi: 10.1016/j.resmic.2016.01.008
Yin, Y., Wang, X., and Zhang, P. (2024). Strategies for improving fengycin production: a review. Microb. Cell Factories 23:144. doi: 10.1186/s12934-024-02425-x
Zhang, B., Xu, L., Ding, J., Wang, M., Ge, R., Zhao, H., et al. (2022). Natural antimicrobial lipopeptides secreted by Bacillus sp. and their application in food preservation, a critical review. Trends Food Sci. Technol. 127, 26–37. doi: 10.1016/j.tifs.2022.06.009
Zhao, G., Sun, T., Zhang, Z., Zhang, J., Bian, Y., Hou, C., et al. (2023). Management of take-all disease caused by Gaeumannomyces graminis var. tritici in wheat through Bacillus subtilis strains. Front. Microbiol. 14:1118176. doi: 10.3389/fmicb.2023.1118176
Zhao, L., Xu, Y., Lai, X.-H., Shan, C., Deng, Z., and Ji, Y. (2015). Screening and characterization of endophytic Bacillus and Paenibacillus strains from medicinal plant Lonicera japonica for use as potential plant growth promoters. Braz. J. Microbiol. 46, 977–989. doi: 10.1590/S1517-838246420140024
Keywords: Bacillus subtilis, Fusarium graminearum, Pyrenophora tritici-repentis, antagonism, biological efficiency, mycological analysis, lipopeptides, mass spectrometric analysis
Citation: Kopiltsov SV, Astapchuk IL, Elisyutikova AV, Nazarenko LV, Kavhiza NJ, Kucher OD, Utkina AO and Rebouh NY (2025) Exploring the potential of new Bacillus subtilis strain VKM B-3516D against common wheat diseases for sustainable farming system. Front. Sustain. Food Syst. 9:1606079. doi: 10.3389/fsufs.2025.1606079
Edited by:
Surekha K. Satpute, Savitribai Phule Pune University, IndiaReviewed by:
Juan Zhang, Ludong University, ChinaMaurice George Ekpenyong, University of Calabar, Nigeria
Bhoomika Karamchandani, University of North Carolina at Charlotte, United States
Copyright © 2025 Kopiltsov, Astapchuk, Elisyutikova, Nazarenko, Kavhiza, Kucher, Utkina and Rebouh. This is an open-access article distributed under the terms of the Creative Commons Attribution License (CC BY). The use, distribution or reproduction in other forums is permitted, provided the original author(s) and the copyright owner(s) are credited and that the original publication in this journal is cited, in accordance with accepted academic practice. No use, distribution or reproduction is permitted which does not comply with these terms.
*Correspondence: Nazih Y. Rebouh, bi55YWNlcjE2QG91dGxvb2suZnI=
 Serguey V. Kopiltsov1
Serguey V. Kopiltsov1 Irina L. Astapchuk
Irina L. Astapchuk Nazih Y. Rebouh
Nazih Y. Rebouh